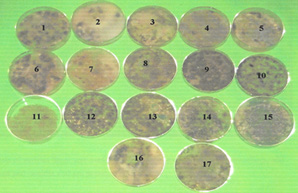
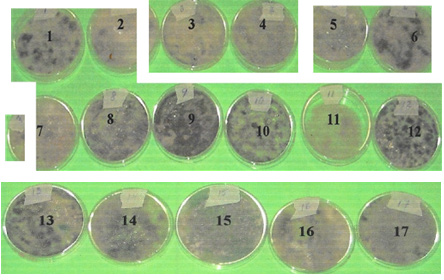

Research Article
Creative Commons, CC-BY
A Potential Bio-pesticide to Control Paddy Bug (Oebalus poecilus) in Guyana
*Corresponding author: Gomathinayagam Subramanian, Divisional of Agriculture Science, University of Guyana Berbice Campus, Tain, Guyana.
Received: February 28, 2025; Published: March 21, 2025
DOI: 10.34297/AJBSR.2025.26.003435
Abstract
The rice industry is an important economic activity for many Guyanese, supporting approximately 20% of the population. With the wave of changing world trade policies, Guyana’s preference is slowly decreasing in the World Trade Organisation, hence it is time to improve productivity and efficiency of rice cultivation. The agriculture sector in Guyana as well as in the Caribbean region continues to face new challenges. Such challenges relate to the need for sustainable production methods and high-quality products, as well as the urgent need to improve competitiveness and extend participation in global markets. Several advanced lines were evaluated, and superior strains are under cultivation in Guyana. Among the various factors influencing the quality and quantity of rice produced, paddy bug Oebalus poecilus is known to be the principal insect pest of rice in Guyana. Biopesticides containing microorganisms (bacterium, fungus, virus, protozoan) as the active ingredients to control pests, are called. microbial pesticides. Microbial pesticides eliminate the threat of chemical pesticides. However, no attempt has been made so far to screen, isolate, and characterise microbial pesticides for the control of paddy bug. In the present research, studies were conducted to screen, isolate, and characterise potential microbes as a biopesticide for the control of paddy bug.
Keywords: Bio pesticides, Paddy bug, Oebalus poecilus, Biological control, Microorganisms
Introduction
The rice Industry is an important economic activity for many Guyanese, supporting approximately 20% of the population. With the wave of changing world trade policies, Guyana’s preference is slowly decreasing in the world trade organisation, hence it is the time for improving productivity and efficiency of rice cultivation. The agriculture sector in Guyana as well as in the Caribbean region continues to face new challenges. Such challenges relate to the need for sustainable production methods and high-quality products, as well as the urgent need to improve competitiveness and extend participation in global markets.
CARICOM members import approximately 350,000 tons of rice annually. Guyana’s major market in this region is Jamaica because it purchases mainly milled white rice, while Trinidad and Tobago are a large importer of parboiled rice. Guyana, traditionally a producer of white rice has some problems in accessing the market. The current short term preferential access to European and CARICOM markets will give Guyana time to improve its rice sector to compete more strongly in a global rice economy by the year 2010. Several advanced lines were evaluated, and superior strains are under cultivation in Guyana. Among the various factors influencing the quality and quantity of rice produced, paddy bug Oebalus poecilus is known to be the principal insect pest of rice in Guyana. In 1927, has reported the paddy bug as a major past of rice in British Guyana. The attack is short duration, but the damage is distinct.
Since 1962, a government sponsored plan has been in operation in British Guyana for the control of pests and diseases. It was recorded by Kennard (1965) [4] that the most important insect pest is Oebalus poecilus which breeds on wild grasses and migrates from them to rice inflowed and subsequently feed and destroy. Oebalus poecilus was first recognised as an important pest at the Caroni Rice Department (CRD) in 1991. By late 1993 Oebalus poecilus was the main pest during the grain filling stage and control measures had been taken in all fields. Ferriara, et al. (2002) [1,2] reported 52.7% loss caused by adults of Oebalus poecilus in the irrigated rice cultivars during spikelet development and maturation. Paddy bug is never eliminated. Integrated pest management (IPM) is the focus for controlling this destructive pest of which biological control could play a major role.
Currently in Guyana and much of South America, stinkbug control has been achieved using monocrotophos, an organophosphate insecticide. In Guyana, 99% of farmers use insecticides and as many as four sprays are applied each season typically by calendar application [5,6]. Approximately 32% of farmers apply insecticides as preventive measures rather than a targeted spray which is not only costly but also has associated with ecological and toxicological hazards. Moreover, farmers in Guyana spray monocrotophos and organo phosphorous insecticides more than the required rate as preventive measures to control the rice bug. This creates environmental pollution and increases cost of cultivation of paddy. It is known that chemicals have destroyed many beneficial insect species and have caused environmental degradation. Therefore, a more balanced, cost effective, eco-friendly approach must be implemented and adopted by rice farmers. Biological control is an innovative, cost effective and eco-friendly approach.
Use of natural enemies (bio pesticides) to control pests is termed biological control. The bio pesticides (also known as biological pesticides) are derived from natural enemies, like parasitoids, predators, plants and microbes. Bio pesticides containing microorganisms (such as, bacterium, fungus, virus, protozoan, or algae) as the active ingredients to control pests, are called microbial pesticides. Microbial pesticides eliminate the threat of chemical pesticides.
The most widely known microbial pesticides are varieties of Bacillus thuringiensis that can control insects of cabbage, potatoes, and other crops. Fungi (such as Beauveria sp. and Metarhizium sp) have been widely used as bio pesticides in Cuba for the control of water weevil. These naturally occurring fungal bio pesticides are environmentally safe, effective and an economical alternative to conventional chemical products. Several microbial pesticides are available for use against insects in green houses.
Paddy bug, popularly known as Ghundi or bush bug is the most destructive rice pest in Guyana and all Caribbean countries. Both the adult and the young nymphs feed on the paddy grains at the milky and dough stages and damage seriously the grain quality and quantity of paddy.
The Guyana Rice Development Board has been experimenting the effectiveness of chemicals in the control of paddy bug. It has listed the weed hosts of paddy bug and in 1999 they have reported Beskia aelops, Coleomegilla maculate (adults and larvae) spiders (all species) and Odonata sp (dragon flies and damsel flies) as natural enemies for the control of paddy bugs. Botanical pesticide neem has been recommended for the control of paddy bug [7] in Guyana. However, no attempt has been made so far to screen, isolate, and characterise microbial pesticides for the control of paddy bug. In this research, importance is given to screen, isolate and characterise potential microbe as bio pesticides for the control of paddy bugs.
Methodology
Screening, Isolation, and Characterisation of Micro-organisms from Soil Sterilisation of Glassware
Selection of glassware was solely for the purpose of making media. Pyrex glassware is better than soda -glass as it is not subjected to corrosion. Glassware was cleaned by soaking overnight in cleaning solution (chromic acid) and then repeatedly rinsed in tap water followed by distilled water. A clean distilled water washed glass rod was used for stirring agar when necessary. Petri plates were washed and subsequently swabbed with methylated spirit and then sterilised in hot air oven at 400° F for 24 hours. Autoclaves and domestic pressure cookers were operated with great care.
Culture Medium for Screening Micro-organisms
Potato dextrose agar (PDA) and PDA medium amended with mascerated rice bug as bait will be used as culture medium. Using selective substrate for screening micro-organisms is called enrichment technique. Potato dextrose broth was used to estimate the dry weight and for preparation of culture filtrate.
Preparation of PDA Amended Bug Mascerate Medium (PDABM)
Potato dextrose agar (PDA) medium was prepared and to this 10g. of mascerated bug extract was added and the volume was made up to 1 Liter. The mixture was distributed into 250 ml flasks autoclaved and stored (as described above). To obtain the bug, extract adult bugs were collected from the rice field and were kept in tight containers to kill them. Dead bugs were weighed (10 g.) and macerated being sterile water just enough to make it pulpy.
Soil Dilution Technique
Using the soil dilution technique micro-organisms [3] were screened on PDABM poured in sterile petri plates. Microorganisms appeared on the above medium on incubation at room temperature. Based on the appearance and colony development, desired organisms were detected and isolated. These organisms which grew in PDABM medium were further screened on higher concentrations (20g.) of bug macerate medium to confirm their stability of rapid colonisation and competency to grow over PDABM medium. Streptomycin Sulphate, 200 ppm., was added to the media after autoclaving. This is a broad-spectrum antibiotic and so it helps to prevent the growth of bacterial colonies and in the process allow fungal colonies to grow and develop without inhibition.
Selection of Bio Pesticide (Microbial Pesticide)
Using the rapid colonisation of the organism as the index, four potential microorganisms -ere selected and type numbered as BP 1, BP 2, BP 3 and BP 4, for experimental purposes. BP1, BP2, BP3 and BP4 were identified based on their taxonomical features.
Preparation of Squash Mounts from Fungal Cultures
Plate cultures were examined under the microscope to determine the areas of sporulation. A drop of the appropriate mountant was placed on a slide. A needle, sterilised by dipping in alcohol, placing in a flame and allowed to cool, was used to remove fungal material very carefully. This fungal material was removed from the needle with the help of a cover slip and transferred to the drop of mountant on the slide. A cover slip was lowered on to the mountant and the slide was flamed gently to remove excess air from the fungal material. It was then cooled on ceramic tile and further checked to ensure that the material was sufficiently free from air bubbles. The release of air because of flaming can cause the spores to become detached from conidiophores so that, while dealing with delicate Hyphomycete e.g., Penicillium, flaming is often best avoided. Using a tissue, the edges of the cover slip were gently pressed to remove excess stain and the area surrounding the cover slip was cleaned and dried. The cover slip was sealed using suitable sealant and the slide was labelled for identification. The four potential fungi identified were as follows:
B P1 - Aspergillus flavus
B P2 - Aspergillus niger
B P3 - Trichoderma harzianum
B P4 - Trichothecium roseum
Petri Plate Bioassay
Radial growth of BPl to BP4 was assayed under in vitro conditions. For each microbe 4 replications were maintained. Radial growth of the fungus was measured at 48 hrs. interval for 7 days and tabulated.
Estimation of Mycelial Dry Weight
Mycelial dry weight of BPl to BP4 were estimated using PDBM broth. Conical flasks 100 ml containing 50 ml liquid broth of PDBM were sterilised and inoculated with known conidial concentration (106 /ml) as inoculum, incubated for seven (7) days, and then filtered using pre-weighed Whatman No. 1 filter paper. Filter paper with mycelia was dried in the incubator at 80°C and weighed. Drying continued until constant weights were obtained. Final weights were estimated as follows: The difference in the filter paper before and after drying was the dry weight of the mycelium.
i. Initial weight of filter paper = X.
ii. Final weight with mycelium after drying = Y.
iii. Mycelium Dry weight = Final Weight - Initial Weight Mycelium Dry weight = (Y - X)
The results were tabulated to compare their rate of growth.
Further BP1 to BP4 were evaluated for the efficacy of paddy bug control. For all experiments the following were the treatments. Uniformly, water served as control treatment.
BP1 Culture filtrate (Aspergillus jlavus)
BP2 Culture filtrate (Aspergillus Niger)
BP3 Culture filtrate (Trichoderma harzianum)
BP4 Culture filtrate (Trichothecium roseum)
WC water control
Preparation of Culture Filtrate
Ten 500 ml conical flasks with 300 ml PDAPB broth were sterilised and then inoculated with 4 discs (8 mm) of seven days old culture and incubated for seven days at room temperature under static conditions. After seven days of incubation, the culture filtrates were collected using sterilised filter system. Collected culture filtrates served as microbial pesticide, hereinafter called microbial insecticide. These culture filtrates were used for foliar spray.
Results and Discussion
Paddy bug is the most significant insect pest in the sector and causes economic losses ranging from five to twenty percent of the national production from most crops. Paddy bug O. poecilus has been raised to a status of concern. Guyana’s President (2006) assured the farmers to have insect zoos to control paddy bugs. Insect zoos intended for keeping the creatures in confined areas on rice fields is the latest initiative by the Guyana Rice Development Board (GRDB) to involve more farmers in the campaign to rid the industry of the destructive paddy bug.
The value of naturally occurring mortality agents, where they occur should be encouraged and their importance should not be underestimated. There are several reports on the excellent performance of microbial pesticides. This form of control is particularly very important and the present research trials using microbial insecticides from Guyana soils is an excellent and outstanding indication to proceed with biological control of the highly damaging paddy bugs. Soil is a growth medium for plants and all living organisms. Soil colour tells us much about some of its other properties. The colour of the surface soil depends mainly on its organic matter content. Darker the soil - more the organic matter.
Reddish and brownish soils indicate good aeration and little waterlogging. Greyish and olive colours indicate much water-logging and chemical reduction of iron. Brownish and grayish colour indicates fluctuating ground water. Soil reaction is expressed as pH.
Soil microorganisms have been screened using seventeen soil samples collected from different places in Guyana. Through serial dilution of seventeen different soil samples, two separate observations were made for bacterial arid fungal colonies. The results are presented in Tables 1 and 2 and Figures 1 and 2.
Identification of various fungi was made based on their growth, colour of mycelium, and conidial head and conidia and are presented in Table 3. Table 4 on the types and number of fungal colonies exhibit interesting observations. The distribution of these fungi varies with soil types. Probably, it depends on the nutrient content of different soil types. Trichoderma harzianum is interestingly dominant in soil types 3,11,13, and 14. Similarly, A. niger dominates in soil types 6, 7, 8, 9, 1 and 2. Radial growth of mycelium of A. flavus, A. niger, T. harzianum, T.roseum on PDABM for seven days at room-temperature are presented in Table 5.
The results on the radial growth of all test fungi clearly indicates their ability to grow fast on bug potato dextrose agar. In seven days of incubation, they cover the whole petri plate. Following radial growth measurement mycelial dry weight was estimated using PD broth under static conditions at room temperature. Four different fungi were tested for paddy bug control. Four replicates were maintained for treatment. Results in Table 6 shows distinct effect of all the microbial. Microbial insecticide tested in the control of paddy bug. On the other hand, water control showed the mycelial of bugs even up to ten days of incubation. Among the four different microbial insecticides tested, T. harzianum showed rapid kill of bugs followed by A.niger, A. flavus and T. roseum. This trial was further tested in the mini plot trial and subjected to statistical analysis (Table 7).
Table 6: Mortality Assessment of Paddy Bug under Pot Culture Conditions against Microbial Insecticides.
Mini plot experiment to evaluate the efficacy of a microbial insecticides on the mortality of bugs, thousand grain weight, chaffy grains, and plant height was conducted at John’s Science Center UGBC and are tabulated in Table 8 and analysed statistically using ANOVA for RCBD (see Table 9).
Conclusion
Soils form different sources inclusive of agricultural field were screened for micro-organisms. Different soils exhibited both fungal and bacterial colonies in different proportions. Fungi were identified based on the colour of mycelia, conidiophores, and conidia. Four fungi, viz, Aspergillus niger, Aspergillus flavus, Trichoderma harziamum and Trichothecium roseum were chose as test fungi, to evaluate their efficacy on the paddy bug as microbial insecticide. All the four fungi were characterised for their stable growth on bug amended PDA Medium. The culture filtrate of the fungi was formulated as microbial insecticide. Microbial insecticide was tested for the mortality of paddy bugs under interval conditions in plastic containers using culture filtrate treated panicles.
Results showed marked effect on the mortality of paddy bags due to microbial insecticide. Paddy bags died in all the microbial insecticide treatment while they were alive in water treatment control at the end of incubation period. Follow laboratory evaluation, pot culture experiments were conducted to confirm the effect of microbial insecticide under interval condition. Results from the pot culture experiment also confirmed the effectiveness of the culture filtrates as microbial insecticide. All the microbial insecticides controlled the survival of paddy bug when compared to water control.
Acknowledgement
None.
Conflict of Interest
None.
References
- Abbott WS (1995) A Method of Computing the Effectiveness of an Insecticide. Journal of Economic Entomology 18(2): 265-267.
- Ferreira E, Viera NR de A, Rangel PHN (2002) Evaluation of damages caused by Oebalus Species in irrigated rice genotypes. Pesquisa Agropecuaria Brasileira 376): 763-768.
- Johnson TR, Case CL (2004) Laboratory Experiments in Microbiology. Pearson Education.
- Kennard CP (1965) Pest and diseases of rice in British Guiana and their control. FAO Plant Protection Bulletin 13(4): 73-78.
- Leboffe MJ, Pierce BE (2016) Microbiology: Laboratory Theory and Application, 4th Edition, MORTON Publishing Company
- Ralph E, Rivas M (1993) Crop Protection Practices in Rice Cultivation in Guyana, Proceedings of a Monitoring Tour and Workshop on Integrated Pest management of rice in the Caribbean. google.com. pp: 145-149.
- Sutherland PJ, Viviane Baharally V, Permaul D (2002) Use of Botanical Insecticides Neem, to control the Small Rice Stink Bug Oebalus poecitus (Dallas 1801) (Hemiptera Pentatamidae) in Guyana. Entomotropica 17(1): 97-101.

We use cookies to ensure you get the best experience on our website.